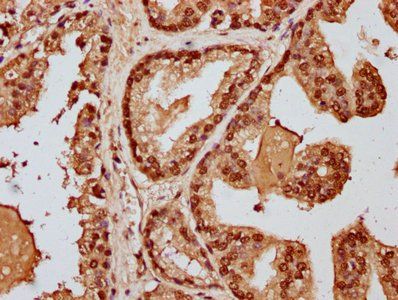
HIST1H3A Antibody

You have no items in your shopping cart.
Search results for: 'Histone H3'
- HIST1H3A Antibody [orb517021]
ELISA, IF, IHC, WB
Human, Mouse, Rat
Rabbit
Polyclonal
Unconjugated
50 μl, 100 μl - HIST1H3A Antibody [orb517080]
ChIP, ELISA, ICC, IF, WB
Human
Rabbit
Polyclonal
Unconjugated
100 μl, 50 μl - HIST1H3A Antibody [orb517048]
ChIP, ELISA, IF, IHC, WB
Human, Mouse, Rat
Rabbit
Polyclonal
Unconjugated
50 μl, 100 μl - HIST1H3A Antibody [orb517066]
ChIP, ELISA, IF, IHC, WB
Human
Rabbit
Polyclonal
Unconjugated
50 μl, 100 μl - HIST1H3A Antibody [orb517083]
ChIP, ELISA, IF, IHC, WB
Human
Rabbit
Polyclonal
Unconjugated
50 μl, 100 μl - HIST1H3A Antibody [orb516374]
ELISA, IF, IHC, IP, WB
Human, Rat
Rabbit
Polyclonal
Unconjugated
50 μl, 100 μl - HIST1H3A Antibody [orb517147]
ELISA, IHC, IP, WB
Human, Mouse, Rat
Rabbit
Polyclonal
Unconjugated
50 μl, 100 μl - Featured
 Histone H3 (phospho Ser28) rabbit pAb Antibody [orb764203]Featured
Histone H3 (phospho Ser28) rabbit pAb Antibody [orb764203]Featured
ELISA, WB
Human, Mouse, Rat
Polyclonal
Unconjugated
100 μl, 50 μl - HIST1H3A Antibody [orb418598]
ELISA, IHC, IP, WB
Human, Mouse, Rat
Rabbit
Polyclonal
Unconjugated
50 μl, 100 μl